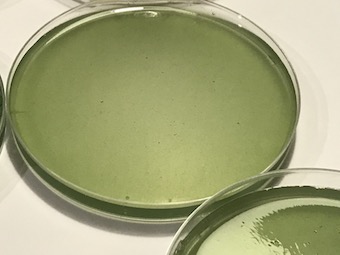
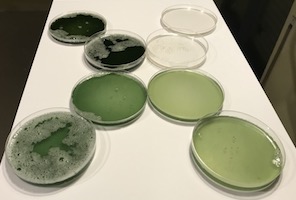
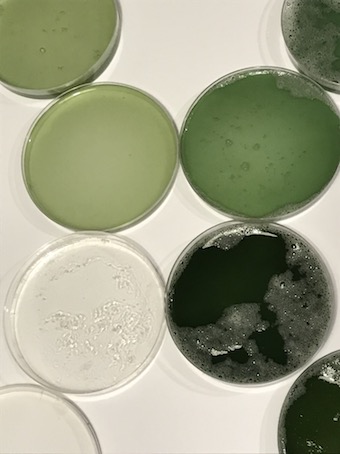
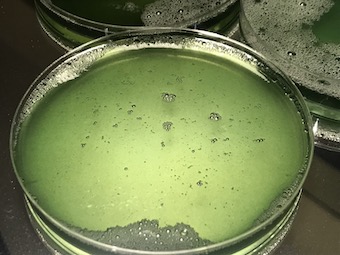

6. Biofabricating¶

This week I worked on crafting and growing different biomaterials.
Agar Agar¶
Agar Agar[^1] is a biopolymer made from agarose (sugar polymer chains). It is found in the cell walls of red algae (Rhodophyta) and has the molecular formula C14H24O9.
Recipes Source : Bioplastic Cook Book by Margaret Dunne|
| Plant Based | ||||
|---|---|---|---|---|
| Glycerine (g) | 0.0 | 14 | 27 | 54 |
| Agar Agar (g) | 16 | 16 | 16 | 16 |
| Water (ml) | 400 | 400 | 400 | 400 |










Agar Agar Foam¶
The only difference between the first recipe of Ager Ager is that after the solution started to boil and bacame viscouse I added a liquid dish soap and whisked the solution until it became foam. It got pretty fast very solid, the same as the ager ager bioplastic.
Recipes Source : Bioplastic Cook Book by Margaret Dunne|
| Plant Based | |
|---|---|
| Glycerine (g) | 27 |
| Agar Agar (g) | 16 |
| Water (ml) | 400 |
| Dish Soap (ml) | 60 |


Gelatine + Spirulina¶
Gelatine[^1] is a biopolymer found in pig skin, ,ade from protein polymer chains of amino acid monomers.It disolves in water, forming a gel substance. Gelatine has this molecular formula: C3H8O3. Spirulina is a type of cyanobacteria (algae). In its dried form it is a green powder.
Recipes Source Bioplastic Cook Book by Margaret Dunne
| Animal Protein Based | ||||
|---|---|---|---|---|
| Glycerine (g) | 0.0 | 3.6 | 7.2 | 14.4 |
| Gelatine Powder(g) | 22 | 22 | 22 | 22 |
| Water (ml) | 100 | 100 | 100 | 100 |
| Spirulina (ml) | 0 | 10 | 30 | 40 |
| Sugar (g) | 8 | 8 | 8 | 8 |

Corn Starch¶
Corn Starch[^1] is composed of amylose and amylopectin polymers. Both consist of glucose (sugar) monomers. It has the molecular formula C27H48O20. Vinegar helps to break down the amylopectin, which allows the dried bioplastic to be more flexible.
Recipes Source Bioplastic Cook Book by Margaret Dunne|
| Plant Based | ||||
|---|---|---|---|---|
| Glycerine (g) | 0.0 | 50 | 100 | 200 |
| Corn Starch (g) | 16 | 16 | 16 | 16 |
| Water (ml) | 800 | 800 | 800 | 800 |
| Vinegar (ml) | 150 | 150 | 150 | 150 |
Agar Agar Bioplastic 2¶
recipe from materiom.org


Chitosan¶
recipe from materiom.org





Sodium Alginate Kombinations¶
recipe from materiom.org






Kombucha¶









In the folowing you can find a table with diffenert recepies and the data about the used materials.
| Bioplastics | Agar Agar | Gelatine | Corn Starch | Agar Ager Foam |
|---|---|---|---|---|
| Plasticiser | Glycerine | Glycerine | Glycerine | Glycerine |
| Biopolymer | Agar Agar | Gelatine | Corn Starch | Agar Agar |
| Solvent | Water | Water | Water | Water |
| Additive | Sugar | Vinegar | Fluid Soap | |
| Colour | Spirulina |
| Recepie Based on | biodegradable | Preparation | Heat | Boiling | Stiring | Froth | Drying | Kombination with | Colour |
|---|---|---|---|---|---|---|---|---|---|
| Agar Agar | Yes | Cold Water | medium | Cell 5 | Cell 6 | remove | on the air | transparent | |
| Agar Agar Foam | Yes | Cell 9 | Cell 10 | Cell 11 | Cell 12 | Cell 11 | on the air | fluid soap | white |
| Agar Agar +Textile | Yes | Cell 9 | Cell 10 | Cell 11 | Cell 12 | Cell 11 | Cell 12 | transparent + textilecolour | |
| Agar Agar +Wool | Yes | Cell 9 | Cell 10 | Cell 11 | Cell 12 | Cell 11 | Cell 12 | transparent + textilecolour | |
| Gelatine | Yes | cold Water | medium | Cell 1 | Until it thickens | remove | Spirulina | Green Shades | |
| Corn Starch | Yes | Cell 9 | Cell 10 | No | Cell 11 | Cell 12 | Cell 11 | ||
| Chitosan | ? | Cell 9 | Cell 10 | Cell 11 | Cell 12 | Cell 11 | Cell 12 | brown | |
| Sodium Alginate | ? | Cell 9 | Cell 10 | Cell 11 | Cell 12 | Cell 11 | 'EggShells' | white | |
| Sodium Alginate | ? | Cell 9 | Cell 10 | Cell 11 | Cell 12 | Cell 11 | 'Coffee powder' | brown | |
| Sodium Alginate | ? | Cell 9 | Cell 10 | Cell 11 | Cell 12 | Cell 11 | 'Peanut Shells' | peanut colour ? | |
| Kombucha | Yes | Cell 9 | Cell 10 | Cell 11 | Cell 12 | Cell 11 | Green Tea | brown | |
| Kombucha | Yes | Cell 9 | Cell 10 | Cell 11 | Cell 12 | Cell 11 | Black Tea | brown | |
| Mycelium | Yes | Cell 9 | Cell 10 | Cell 11 | Cell 12 | Cell 11 | Cell 12 | bright brown |
Preparation in the upper table means how the ingredients are to be mixed in the begining, bevore further treatment. Heat sould give the short information abot the kind of heat supply. Boiling shoud give the information about how long the fluid should be boild at given temperature.
[^1]: All descriptions taken from the Bioplastic Cook Book.